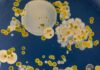
Парадокси в лечението с антибиотици и как губим битката срещу бактериите

Чехкиня е новата Мис Свят
Кристина Пишкова от Чешката република спечели 71-ия международен конкурс за красота "Мис Свят 2024". Първата вицемис беше Ясмина Зайтун от Ливан. Конкурсът се проведе...
Картина на Фрида Кало може да счупи рекорд за най-скъпо произведение
Една по-малко позната картина на Фрида Кало, известна с провокативните си автопортрети, ще бъде предложена на търг в аукционната къща "Сотбис", като се очаква продажбата...
С критика към Тръмп: Обама рапира култов хит на Еминем
Барак Обама рапира култовия хит на Еминем Lose Yourself пред тълпа в Детройт по време на предизборен митинг за Камала Харис, пише The Guardian.
Той беше предшестван от самия Еминем, който...
Странната близост между фамилиите Трюдо и Кастро
Канадският премиер Джъстин Трюдо отново е под светлината на прожекторите, след като обяви, че подава оставка. Турбулентната му политическа кариера беше белязана и от...
30 ГОДИНИ ОТ НАЧАЛОТО НА ПЪРВОТО ТВ МОДНО ПРЕДАВАНЕ У НАС
Академията за мода отбеляза подобаващо юбилея на „Блясък“
Участниците (дизайнери и модели) във Вечерта на стила, посветена на първотобългарско телевизионно предаване за мода „Блясък“.Фото: Академия...
Модните къщи с милиони евро загуба след затварянето на руските си бутици
Френската модна къща Louis Vuitton е понесла загуби от 11 млн. евро през 2024 г. заради затварянето на своите магазини в Русия, съобщава Telegram-каналът Mash. Загуби от напускането на руския...
На 89 години почина една от най-големите звезди на Холивуд – Робърт Редфорд
Знаменитият американски актьор и режисьор Робърт Редфорд е починал рано сутринта в дома си в Юта. Той беше на 89 години, съобщава "Ню Йорк таймс".
Информацията...
Кейт Мидълтън с първа публична поява след диагностицирането с рак
Кейт Мидълтън, принцесата на Уелс, направи своята дългоочаквана първа публична изява за годината на традиционния военен парад Trooping the Colour по случай рождения ден...
Косата на Кейт Мидълтън остава гъста и красива дори след химиотерапия
Тази събота принцесата на Уелс и съпруга на британския престолонаследник принц Уилям - Кейт Мидълтън - застана пред камерата за първата си публична поява за последните...
Заради дългове: Продадоха часовника, подарен на Джина Лолобриджида от Фидел Кастро
Часовник на Джина Лолобриджида - подарък от кубинския лидер Фидел Кастро, беше продаден на търг с нейни вещи в Генуа за 18 850 евро, съобщи...